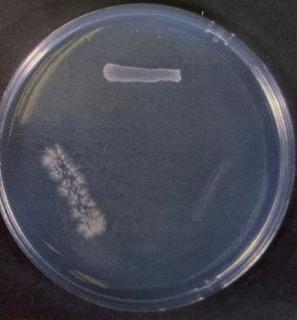
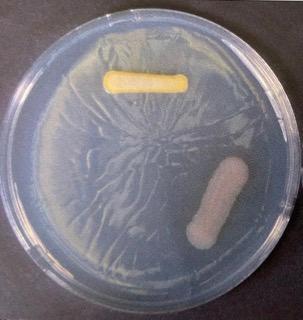
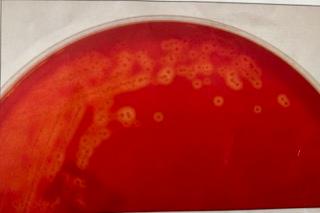
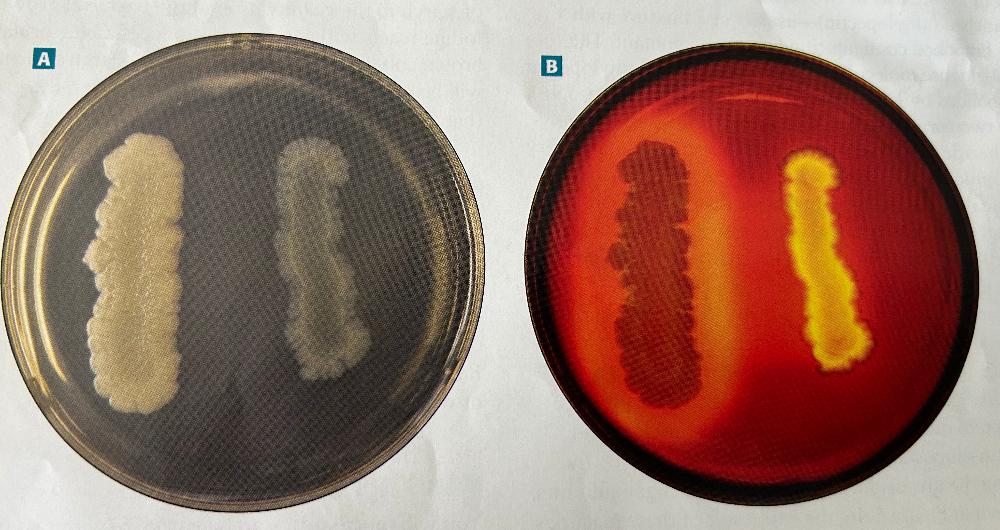

Exercise 2-8: Anaerobic Jar
Plate was inoculated inside the jar
Facultative anaerobe = top; strict aerobe = right; strict anaerobe = left
Exercise 2-8: Aerobic Jar
Plate was inoculated outside the jar
Facultative anaerobe = top; strict aerobe = right; strict anaerobe = left

Exercise 2-3: Growth Patterns on Slants
From left to right:
1). flat, dry
2). spreading edge
3). crusty/friable
4). transparent/barely visible

Exercise 2-4: Growth patterns in broth
From left to right: in pairs
1 & 2). uniform fine turbidity
3 & 4). sediment (stuff at the bottom)
5 & 6). pellicle (stuff floating on top)

Exercise 5-4: Methyl Red test results
Left to right:
1. red color = positive result (mixed acid fermentation)
2. no color change = negative result (no mixed acid fermentation)

Exercise 5-4: Voges-Proskauer test results
Left to right:
1. no color change = negative result (no 2,3-butanediol fermentation w/ no acetoin produced)
2. red color = positive result (2,3 - butanediol fermentation w/ acetoin produced)

Exercise 5-5: ONPG test
Left to right:
1. Yellow color formation = positive result (organism produces B-galactosidase)
2. No color change = negative result (organism does not produce B-galactosidase)

Exercise 5-28: Motility Test
Left to right:
1. red diffuse growth radiating outward from the stab line = positive result (organism is motile)
2. red growth only along the stab line = negative result (organism is nonmotile)

Exercise 5-25: Blood Agar
no hemolysis: no change in the medium = organism doe snot hemolyze RBCs

Exercise 5-25: Blood Agar
alpha-hemolysis
- cant see it on photo but has green tint to it
alpha-hemolysis: greening around the growth = organism hemolyses RBCs partially
Exercise 5-25: Blood Agar
B-hemolysis: clearing around growth = organism hemolyses RBC's completely
Exercise 5-21: Triple sugar Iron Agar/Kligler Iron Agar
Other result interpretations not seen in image
1. A/A TSIA
2. K/K
3. NC/NC
1. yellow/yellow = glucose and lactose and/or sucrose fermentation w/ acid accumulation in slant and butt
2. red slant/red butt = no fermentation; peptone catabolized aerobically and anaerobically w/ alkaline products; not from Enterobacteriaceae family
3. No change/no change = organism is growing slowly or not at all; not from Enterobacteriaceae family

Exercise 5-21: Triple sugar Iron Agar/Kligler Iron Agar
Left to right: are all KIA slants (TSIA tubes w/ same appearance are scored the same)
1. red slant/yellow but = K/A (glucose fermentation w/ acid production; proteins catabolized aerobically in the slant w/ alkaline products)
2. red slant/no change in butt = K/NC (no fermentation; peptone catabolized aerobically w/ alkaline products; not from Enterobacteriaceae)
3. Uninoculated control
4. black predicate in the agar = H2S (sulfur reduction which is an acid condition from fermentation of glucose & lactose)
5. yellow slant/yellow butt = A/A (glucose and lactose fermentation w/ acid accumulation in slant and butt)
- also cracks in/or lifting of the agar = G (gas production)
Exercise 5-13: Starch Hydrolysis (Amylase test)
- are you supposed to read results after or before reading iodine?
Left to right: read results after adding iodine (B)
1. Clearing around growth (halo) = positive result (alpha-amylase and/or oligo-1,6-glucosidase is present)
2. no clearing around growth = negative result (neither alpha-amylase or oligo-1,6-glucosidase is present)

Exercise 5-16: Casein Hydrolysis (Casease test)
Bottom to top:
1. no clearing in the agar = negative result (casease is absent)
2. clearing in agar = positive result (casease is present)

Exercise 5-20: SIM Medium Sulfur Reduction
left to right:
1. no black in the medium = negative result (sulfur is not reduced)
2. black in the medium = positive result (sulfur reduction w/ H2S production)

Exercise 5-20: SIM Medium Indole Production
left to right:
1. Reagent color is unchanged = negative result (organism doesn't produce tryptophanase and tryptophan is not hydrolyzed)
2. red in the alcohol layer of kovac's reagent = positive result (organism produces tryptophanase and hydrolyzes tryptophan into indole and pyruvate)

Exercise 5-20: SIM Medium Motility
left to right:
1. no radiating growth = negative result (nonmotile)
2. growth radiation outward from stab line = positive result (motile)
notice: if there is a blackened medium (H2S produced), motility cannot be determined (ND)

Exercise 5-11: Decarboxylation test
- media was made w/ lysine
left to right:
1. yellow = negative result (fermentation; no decarboxylation)
2. uninoculated control
no color change = negative (no decarboxylation)
3. purple (may be slight) = positive result (decarboxylation; organism produces the specific decarboxylase enzyme)

Exercise 5-7: Oxidase test
Left to right:
1. dark blue/purple within 20 seconds = positive result (cytochrome c oxidase is present)
2. no color change to blue/purple within 20 seconds = negative results (cytochrome c oxidase not present)

Exercise 5-6: Catalase Test
Left to right:
1. no bubbles = negative result (catalase is absent)
2. bubbles = positive result (catalase is present)

Exercise 5-17: Gelatin Hydrolysis
Top to bottom: they are kinda upside down so read right to left
1. gelatin is liquid (control is solid) = positive result (gelatinase is present)
2. gelatin is solid = negative result (no gelatinase is present)

Exercise 5-9: Citrate Utilization test
Left to right:
1. no color change & no growth = negative result (citrate is not utilized)
2. uninoculated control
3. blue (even a small amount) = positive result (citrate is utilized)
also have: no color change & growth = positive result (citrate is utilized)

Exercise 5-3: PR broths
1. yellow broth, bubble in tube (A/G) = fermentation w acid and gas end products
2. yellow broth, no bubble in tube (A/-) = fermentation w/ acid end products; no gas produced
3. uninoculated control
4. red broth, no bubble in tube (-/-) = no fermentaton
5. pink broth, no bubble in tube (K) = degradation of peptone; alkaline end products

Exercise 5-12: Phenylalanine Deaminase Test
1. green color = positive result (phenylalanine deaminase is present)
2. uninoculated control
3. no color change = negative result (phenylalanine deaminase is absent)

Exercise 5-8: Nitrate Reduction test
- broth before addition of reagents
2. uninoculated control
5. gas (non-fermenter) = positive result (denitrification - production of nitrogen gas)

Exercise 5-8: Nitrate Reduction test
- after addition of reagents
1. Red color (after addition of reagants A and B) = positive result (nitrate reduction to nitrite; nitrate reductase is present)
3. no color change (after the addition of reagants A and B) = incomplete test; requires the addition of zinc dust
4. no color change (after the addition of reagants A and B) = incomplete test; requires the addition of zinc dust

Exercise 5-8: Nitrate Reduction test
3. red color (after addition of zinc dust) = negative result (no nitrate reduction)
4. no color change (after addition of zinc dust) = positive result (nitrate reduction to nongaseous nitrogenous compounds)

Exercise 5-18: Urea Hydrolysis (Urease test)
1. orange or yellow (24h) to orange or yellow (6 days) = negative result (no urea hydrolysis; urea is absent)
2. uninoculated control
3. all pink (24h) = positive result (rapid urea hydrolysis; strong urease production)
also have partially pink or orange/yellow (24h) to all pink or partially pink (6 days) = weak positive result (slow urea hydrolysis; weak urease production)

Exercise 4-4: Mannitol Salt Agar
top to bottom:
1. yellow growth or halo (Y) = organism produces acid from mannitol fermentation and is likely pathogenic Staphylococcus aureus
1a. good growth (G) = organism is not inhibited by NaCl
2. red growth (no halo) (R) = organism does not ferment mannitol and is Staphylococcus other than S.aureus
2a. good growth (G) = organism is not inhibited by NaCl
also have poor growth (P) or no growth (N) = organism is inhibited by NaCl & is not Staphylococcus

Exercise 4-1: Phenylethyl Alcohol Agar
top/bottom are gram(+) and left/right gram(-):
1. good growth (G) = organism is not inhibited by phenylethyl alcohol and is a probable Staphylococcus, Streptococcus, Enterococcus, or Lactococcus
2. poor growth (P) or no growth (N) = organism is inhibited by phenylethyl alcohol and is a probably gram(-) organism

Exercise 4-5: MacConkey Agar
left/right are gram(+) cocci and top/bottom are gram(-) Enterobacteriaceae:
1. poor growth (P) or no growth (N) = organism is inhibited by crystal violet and or/bile and is gram(+)
2. poor growth (P) or no growth (N) = organism is inhibited by crystal violet and or/bile and is gram(+)
3. good growth (G) = organism is not inhibited by crystal violet or bile and is gram(-)
3a. pink to red growth w/ or w/o bile predicate = organism produces acid from lactose fermentation and is a probable coliform
4. good growth (G) = organism is not inhibited by crystal violet or bile and is gram(-)
4a. growth is "colorless" aka not red or pink (C) = organism does not ferment lactose and is a noncoliform

Exercise 4-6: Eosin Methylene Blue Agar (Levine)
Left/right are gram(+) cocci and top/bottom are Enterobacteriaceae w/ a conform on top and a noncoliform at the bottom
1. poor growth (P) or no growth (N) = organism is inhibited by eosin and/or methylene blue and is gram(+)
2. poor growth (P) or no growth (N) = organism is inhibited by eosin and/or methylene blue and is gram(+)
3. good growth (G) = organism is not inhibited by eosin and methylene blue and is gram(-)
3a. growth is "dark" (purple to back, w/ or w/o green metallic sheen) (D) = organism ferments lactose and/or sucrose w/ acid production and is a possible coliform
4. good growth (G) = organism is not inhibited by eosin and methylene blue and is gram(-)
4a. growth is "colorless" aka not red or pink (C)= organism does not ferment lactose and is a noncoliform
Exercise 9-10: Capsule Stain
- explain the process

if capsules are present, they will appear white against a stained background
Exercise 3-6: Negative Stains
- explain the process

always stain background with acidic dye
(circles are air bubbles)
- used to measure cell size and shape
Exercise 3-7: Gram Stain
- explain the process

Positive = walls have a lot of peptidoglycan
Negative = not a lot of peptidoglycan in walls (and prescense of cell membrane)
Aerotolerance categories

Exercise 3-10: Endospore Stain
- explain the process
